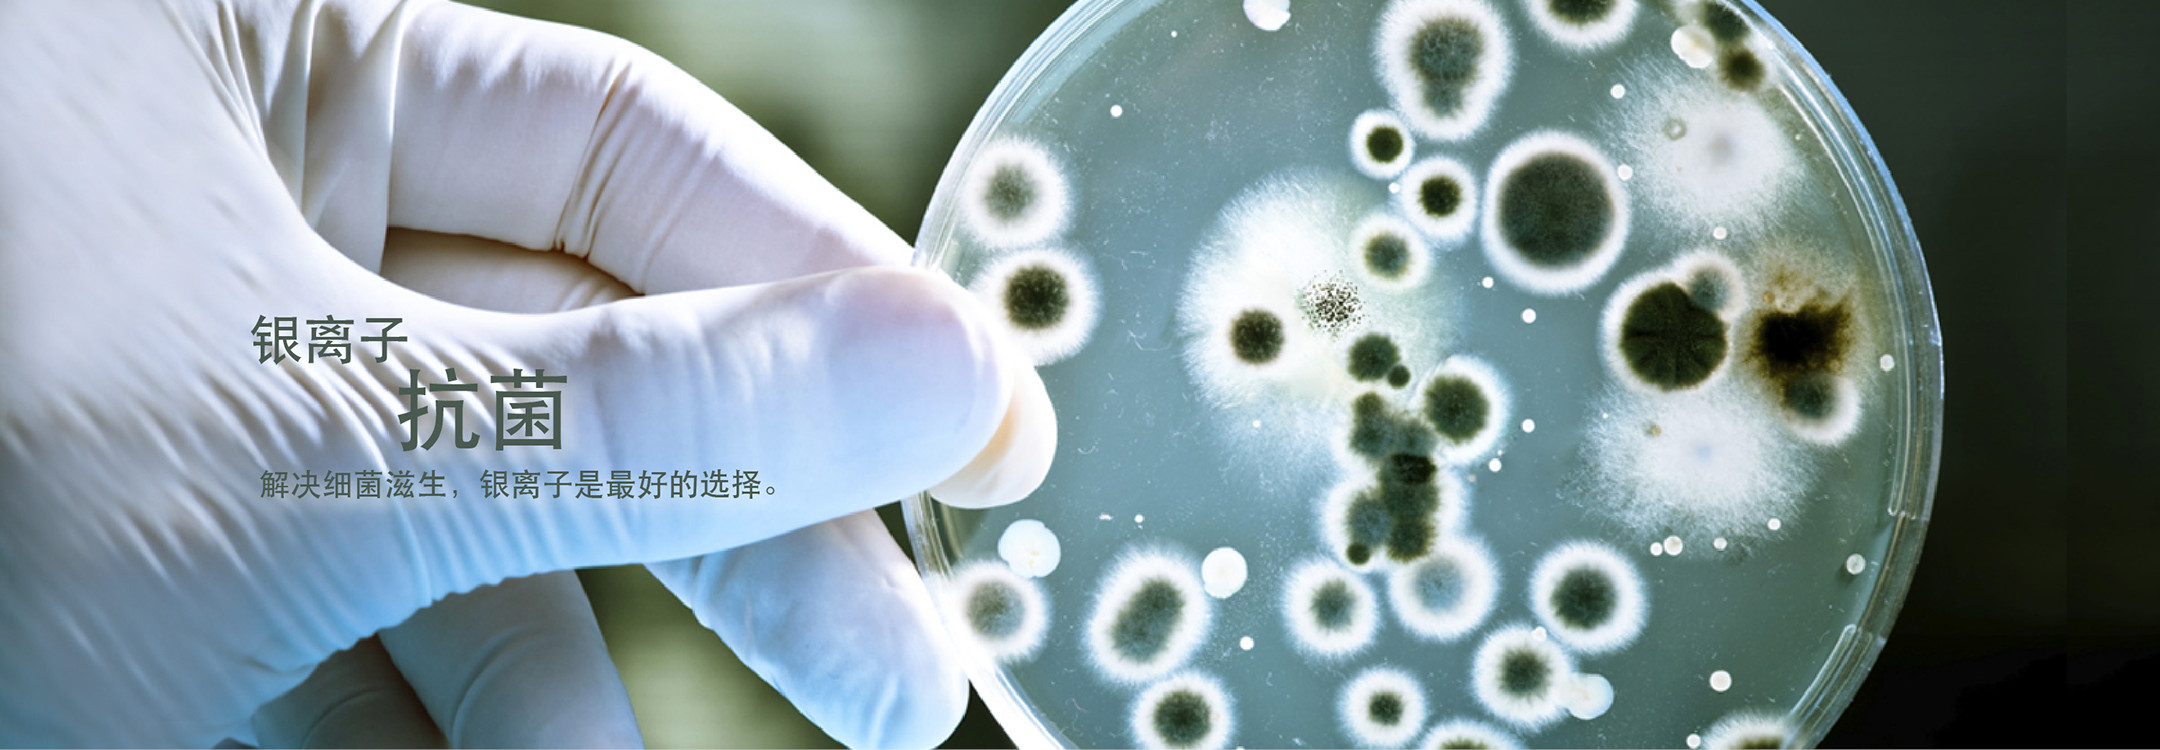
抗菌防霉,生物降解

地址:广东省深圳市宝安区沙井街道坣岗大道文体中心2202室 电话:0755-82559816 电邮:info@envisage.hk
展恒凯文科技(深圳)有限责任公司©2017 版权所有 不得转载-粤ICP备2021102517号














地址:广东省深圳市宝安区沙井街道坣岗大道文体中心2202室 电话:0755-82559816 电邮:info@envisage.hk
展恒凯文科技(深圳)有限责任公司©2017 版权所有 不得转载-粤ICP备2021102517号

3.jpg?crc=239768787)
.jpg?crc=3781616217)
.jpg?crc=3909371609)











3.jpg?crc=239768787)
.jpg?crc=3781616217)
.jpg?crc=3909371609)











3.jpg?crc=239768787)
.jpg?crc=3781616217)
.jpg?crc=3909371609)










